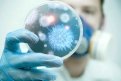
Фото: domashniy.ru

Фото: domashniy.ru— Анжела Олеговна, что это за заболевание такое — дисбактериоз?
— Это заболевание связано с изменением состава микрофлоры кишечника. При дисбактериозе наблюдается избыточный рост бактерий в тонком кишечнике и происходит дисбаланс микрофлоры в толстом кишечнике.
— По каким-то признакам можно распознать у себя дисбактериоз?
— Да. По таким признакам, как частое расстройство стула, метеоризм — то есть вздутие живота, повышенное газообразование, когда живот «надут» как барабан. Следующий признак — урчание в животе. И конечно, когда живот переполнен газами, когда пища переваривается не так, как надо, возникают боли в животе.
— В чем, кроме неприятных ощущений, опасность дисбактериоза?
— При дисбактериозе кишечника расстраивается процесс всасывания пищевых веществ, они усваиваются не полностью, а продукты распада остается в кишечнике, образуются токсины. Из-за этого всегда страдает общее самочувствие, у такого человека развивается астено-невротический синдром. Он проявляется такими признаками, как слабость, быстрая утомляемость, снижение работоспособности, ухудшение сна, головная боль. Как правило, они появляются, когда у человека уже длительное время наблюдается дисбактериоз кишечника
— Выходит, от работы кишечника, зависит общее самочувствие человека?
— Да, и это не удивительно. Там кипит своя особая жизнь. Если вы хорошо питаетесь, то есть снабжаете свой кишечник правильными продуктами — то все, что нужно, будет перевариваться, все, что не нужно — выводиться. А если образ жизни у вас нездоровый, питание плохое, некачественное — нарушается баланс, дружественная микрофлора погибает и начинает развиваться дисбактериоз.
— Но ведь микрофлора — это микроскопические, невидимые глазу организмы. Так ли уж важно, как им у нас «живется»?
— В это трудно поверить, но численность микроорганизмов в теле человека намного превышает численность его собственных клеток. В одной только толстой кишке от 35 до 50 процентов содержимого — это микрофлора, ее масса — от 1 до 3 килограммов. И, конечно, без нее человек просто не смог бы существовать. Образно выражаясь, представители полезной микрофлоры — это хозяева нашего кишечника. И как заботливые хозяева, они ухаживают за своим «домом», убирают «мусор», наводят порядок и красоту, делают все, чтобы в доме было хорошо и уютно.
— Какую функцию выполняет полезная микрофлора?
— Если говорить о функциях, они разнообразны. Это и расщепление ранее не переваренных компонентов пищи — даже белки расщепляются в толстом кишечнике с помощью микрофлоры. Следующая функция — образование веществ, питающих клетки кишечника, а также веществ, которые подавляют патогенную микрофлору. Например, полезная микрофлора в процессе жизнедеятельности образует молочную кислоту, которая вытесняет ее врагов, участвует в образовании витамина К и целого созвездия витаминов группы В. В принципе витамины не образуются организмом человека, но вот витамины группы В как раз образуются в толстом кишечнике полезной микрофлорой. И она на 70 процентов может взять на себя образование витаминов этой группы. Поэтому, если вы даже каких-то витаминов группы В недополучаете — например, с крупами или мясом — но у вас хорошо работает кишечник, он этот дефицит компенсирует.
— Настолько важны для человека витамины группы В?
— От них зависит состояние кожи, волос, нервной системы и та энергия, которую мы чувствуем в течение дня. Это энергетический котел нашего организма! То есть это очень важная группа витаминов. Так что спасибо полезной микрофлоре за то, что она нас снабжает ими!
«Амурская правда» в соцсетях:
— Над чем еще трудится полезная микрофлора?
— Она стимулирует иммунную функцию лимфатической ткани. Потому что основное количество лимфатической ткани человека находится в стенке кишечника. И способность организма подавлять чужеродные агенты напрямую зависит от состояния микрофлоры.
— А как связан дисбактериоз с расстройством стула?
— Формирование стула — это одна из важных функций полезной микрофлоры. От ее состояния зависит способность слизистой кишечника нормально выполнять свои функции. Хорошо работает микрофлора — человек имеет хороший стул и не имеет никаких неприятных ощущений. Дисбактериоз не является причиной заболеваний желудочно-кишечного тракта, он — следствие этих заболеваний, пищеварительных расстройств. То есть дисбактериоз всегда вторичен.

— Каковы причины возникновения дисбактериоза?
— Первая причина дисбактериоза толстой кишки — это кишечная инфекция. Поехали куда-то в отпуск, купили на улице еду, которая была обсеменена инфекцией, съели — и заразились этими инфекциями. Если появились боли в животе, жидкий стул, температура — значит, у вас острая пищевая токсикоинфекция. Эти инфекции приводят к дисбактериозам.
Следующая причина — прием антибиотиков. Специалисты не устают говорить, что бесконтрольный прием антибиотиков не допускается! Потому что они нарушают состояние микрофлоры. Их назначают только тогда, когда без них не обойтись. Не нужно глотать такие лекарства «на всякий случай». И если врач назначает антибиотики, он должен назначить профилактический прием препаратов, которые сразу будут восстанавливать состояние микрофлоры кишечника.
Еще одна причина — длительный прием некоторых лекарств. Это обычно бывает при лечении каких-то тяжелых хронических заболеваний. Многие препараты при длительном применении вызывают такие побочные явления, как нарушение баланса микрофлоры.
— А какие-то другие заболевания могут повлиять на состояние микрофлоры?
— Да, конечно. К дисбактериозу может привести синдром раздраженной толстой кишки. Этот диагноз ставить терапевт или гастроэнтеролог. И человек с таким заболеванием уже в группе риска по дисбактериозу. Любые хронические заболевания желудочно-кишечного тракта могут вызывать дисбактериоз, в том числе и колиты, панкреатиты, холециститы и так далее.
— А если человек питается кое-как, без режима, это может сказаться на состоянии микрофлоры?
— Обязательно! Это лишь вопрос времени. Кто-то считает, что удобно перекусывать бутербродами и кофе. Но это неправильно. Пища должна быть полноценной. И принимать ее желательно с определенной частотой и в одно и то же время. А если количество и качество еды постоянно меняется — жди дисбактериоза.

— А какие продукты «любит» микрофлора?
— Полезным бактериям необходима клетчатка, то есть овощи и бобовые. Но если кто-то вдруг начнет их употреблять в слишком больших количествах, то кишечнику это может не понравиться.
— Почему, если это полезно?
— Если в организме какая-то функция долго не эксплуатировалась, то она просто атрофируется. Если человек долгое время употреблял пищу выхолощенную, очищенную, которая содержала мало клетчатки, то даже тарелка овсяной каши вызовет бурную реакцию. Поэтому количество овощей, круп, бобовых в рационе нужно увеличивать постепенно.
— А популярное у некоторых голодание микрофлоре нравится?
— Продолжительные голодания тоже могут вызвать дисбактериоз толстой кишки. Физические и психические стрессы могут неблагоприятно повлиять на состояние кишечника. И даже гидроколонотерапия — то есть глубокое очищение кишечника с помощью воды — должна назначаться только по строгим показаниям опытного врача-гастроэнтеролога, а не косметологом, например, как модная процедура. Если оно проводится часто и без строгих показаний, то может буквально вымыть нормальную микрофлору толстой кишки.
— Как лечится дисбактериоз?
— Прежде всего лечится заболевание, которое его вызвало. Врач внимательно изучает, какая причина может быть в основе дисбактериоза толстого кишечника, и он должен отработать это заболевание. Если у человека были такие причины, как кишечные инфекции или длительный прием антибиотиков, то сразу назначаются препараты, восстанавливающие полезную микрофлору. Если дисбактериоз появился в результате нездорового образа жизни — исправляем образ жизни, а потом восстанавливаем функцию кишечника. Также необходимо употреблять как продукты обычные, так и биопродукты, которые имеют оздоровительное действие на кишечник, на состояние микрофлоры. Врач может порекомендовать пробиотики и пребиотики. И лишь по особым показаниям он может назначить антибактериальные средства для того, чтобы подавить патогенную микрофлору.
— Что такое пробиотики и пребиотики? На слух это почти одно и то же…
— Пробиотики — это живые, полезные для кишечника микроорганизмы. Слово переводится как «вещества для жизни», а вот антибиотики как раз «против жизни». Пробиотики — это представители нормальной микрофлоры кишечника, в основном бифидобактерии и лактобактерии. Их еще называют эобиотиками.
— То есть это — всевозможные йогурты, кисломолочные продукты?
— Да. Но есть еще и лекарственные препараты, которые содержат бифидобактерии и лактобактерии. Их, конечно же, назначает врач.

— С пробиотиками разобрались. А что такое пребиотики?
— Это вещества или компоненты пищи, которые не перевариваются, но именно они стимулируют рост, развитие и биологическую активность полезной кишечной микрофлоры. Например, пищевые волокна, которые необходимы для здоровья микрофлоры. Так же к пребиотикам относятся некоторые виды полисахаридов — то есть углеводистые соединения. Например, инулин. Он не расщепляется в желудке, а когда доходит до толстого кишечника, микрофлора начинает его с удовольствием расщеплять. Можно сказать, что она на нем растет и развивается. Для образности приведу такой пример: представьте хилого человек, который не развивал мускулатуру, плохо питался, а потом вдруг стал потреблять полезную пищу, принялся заниматься физическими упражнениями и превратился в бодибилдера. Вот так же точно чувствует себя наша микрофлора, когда мы даем ей хорошее качественное питание — пищевые волокна и инулин.
— Какие вещества еще относятся к пребиотикам?
— Лактулоза. Это полисахарид, который входит в небольших количествах в состав многих лекарств. А вообще его используют для стимуляции роста полезной микрофлоры, для хорошей работы кишечника, то есть он обладает и слабительным действием. В этом качестве препараты с лактулозой считаются наиболее безопасными для людей, страдающих запорами, особенно для пожилых, для лежачих. Оптимально, когда в одном препарате сочетаются и пробиотики и пребиотики — это уже так называемые симбиотики.
— Эти лекарства должен назначать врач?
— Самолечением в XXI веке заниматься нелепо. С любой проблемой, которая касается здоровья, нужно обращаться к доктору! Сейчас есть все необходимое, чтобы и найти проблему, и решить ее. По крайней мере ту, которая касается здоровой микрофлоры кишечника.

Специалисты из Новосибирска помогли амурским врачам провести сложные операции на сердце
В течение 6 месяцев урчит в животе,анализ на дисбактериоз-почти в норме-небольшие отклонения.Запоры,пью минеральную воду Donat с магнием.Никакие слабительные не помогают.Спасаюсь свечами с глицерином.
Как можно помочь в данном вопросе?
— ar_temой, у меня часто такое(( особенно сидишь на учебе/на работе, и тут на тебе( песня кита... так стыдно и неловко становится, жуть! а вот от кисломолочных продуктов плоховато становится.. даже не знаю, что и делать, только к врачу остается идти? а вообще почему урчит в животе? он поёт :) а еще я нашла одну статью, там даже звуки есть по этой теме, можете послушать и научиться распознавать проблемы живота) https://medvisor.ru/articles/gastroenterologiya/gromkie-zvuki-v-zhivote/
— no5ova.dariaДисбактериоз — это не болезнь. Ее нет в перечне медицинских заболеваний. Нарушение баланса состава микрофлоры приводит к тому, что ослабляется у человека иммунитет, он становится подвержен воздействию различных вирусов. Для того чтобы баланс бактерий остановить, достаточно ежедневно принимать пробиотики. Мне нравится Здоровье фирмы Бакздрав. В его составе есть большое количество различных штаммов, что позволяет не только наладить микрофлору, но и улучшить защитные свойства организма.
— Марина32 (гость)